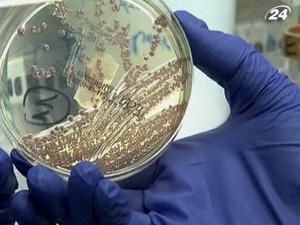
Первый случай заражения E.coli обнаружили в Польше Первый случай заражения E.coli обнаружили в Польше

Сообщается, что инфицированная постоянно проживала в Германии. Также стало известно, что с подозрением на заболевание госпитализированы еще двое поляков.
Тем временем стало известно, что вероятным источником бактерии могли быть ростки сои, а не огурцы или помидоры, как сообщалось ранее. Информацию подтвердил министр сельского хозяйства земли Нижняя Саксония Герт Линдеманн.
Впрочем, о точных результатах исследования бактериологи планируют сообщить позже. Напомним, жертвами кишечной инфекции уже стали 22 человека, более 2 тысяч человек - инфицированы.
Фермеры из стран ЕС понесли рекордные убытки, ведь спрос на их продукцию упал практически до нуля. Для того, чтобы помочь производителям сельскохозяйственной продукции, во вторник министры сельского хозяйства стран ЕС соберутся на внеочередное совещание. О вероятной сумме возмещения пока не сообщают.